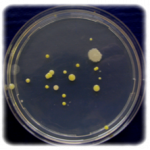

Keimzahlbestimmung nach ISO 8573-7:2003 und DIN EN ISO 62222
Keimzahlanalyse
Keimzahlbestimmung durch Probenahme und Auswertung eines akkreditierten Labors nach ISO 8573-7:2003 und DIN EN ISO 62222
Die Probe kann durch einen Druckluftfachhändler oder den Anwender direkt genommen werden.
Dank des übersichtlichen Probenahmekoffers ist jeder Schritt zur erfolgreichen Probenahme ausführlich beschrieben.
Der speziell entwickelte Filterhalter beinhaltet ein Filterpapier, welches mit der Druckluft belüftet wird.
Dieses Filterpapier wird im Labor bebrütet, um die enthaltenen Bakterien- und Pilzkulturen analysieren zu können.

Downloads
Weitere Produkte
Wie können wir Ihnen Helfen?
Wir freuen uns auf Ihren Anruf oder Ihre Mail und stehen Ihnen gerne mit Rat und Tat zur Seite!
02154 / 88 73 80 - 0
Mo - Fr von 7 bis 17 Uhr